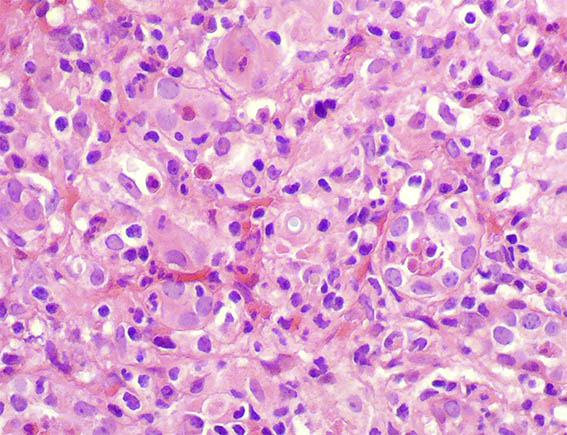
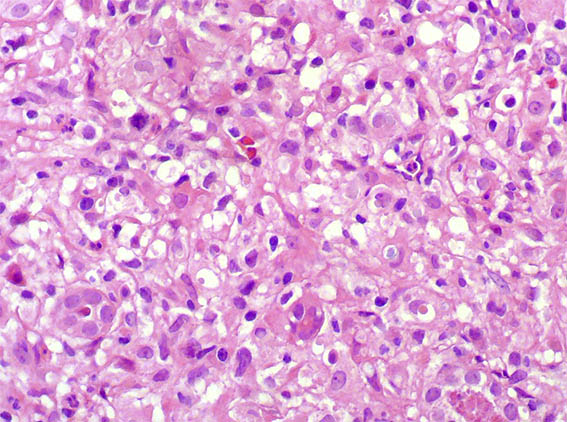
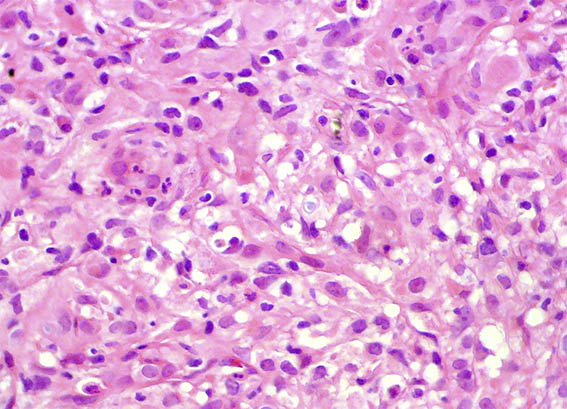

|
|
CASE
106 (December 2014)
Clinical information
A five month-old girl presented with symptoms of malnutrition and severe urinary tract infection, with signs of sepsis and acute renal failure: serum creatinine 1.4 mg/dL. Both blood and urine cultures were positive for Escherichia coli, and antibiotic therapy was started. Severe, almost symmetrical, bilateral nephromegaly was evident on computed tomography (Figures 1 and 2). Voiding cystourethrography showed no urinary tract abnormalities.
Bilateral renal biopsies were performed.See the images.

Figure 1.

Figure 2.
Figure 3. H&E, X400.

Figure 4. H&E, X400.
Figure 5. H&E, X400.
Figure 6. H&E, X400.

Figure 7. PAS, X400.

Figure 8. PAS, X400.
What is your diagnosis?
See
diagnosis and discussion
[Top]
|
|